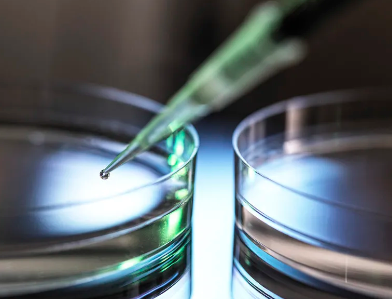
image.png

濰坊哪家幹細胞醫院口碑最佳?
2024-10-25 11:26:23 來源: 小編 咨詢醫生
在我國,幹細胞治療作爲一種前沿的生物技術,已經得到了越來越多的關注。幹細胞療法在治療某些疾病方面具有顯著的效果,因此,許多人都在尋找口碑最佳的幹細胞醫院。接下來,我們就來了解一下濰坊地區哪家幹細胞醫院的口碑最佳。
首先,我們要了解幹細胞醫院的選擇标準。
一家優質的幹細胞醫院應當具備以下特點:
1.專業的醫療團隊:幹細胞治療需要專業的醫療人員操作,因此,醫院的醫療團隊實力是衡量其口碑的重要标準。
2.先進的設備和技術:幹細胞治療需要先進的設備和技術支持,以确保治療過程的安全性和有效性。
3.完善的服務體系:優質的服務體系能夠爲患者提供舒适的就醫環境,讓患者在治療過程中感受到關愛。
4.良好的口碑:口碑是衡量一家醫院實力的直觀體現,良好的口碑意味着醫院在行業内具有較高的認可度。
接下來,我們根據以上标準來分析濰坊地區的幹細胞醫院。
1.濰坊市人民醫院:作爲一家三甲等醫院,濰坊市人民醫院在幹細胞治療領域擁有豐富的經驗。醫院擁有一支專業的醫療團隊,先進的設備和技術,以及完善的服務體系。在患者口碑方面,濰坊市人民醫院也具有較高的認可度。
2.濰坊市中醫院:濰坊市中醫院在幹細胞治療方面同樣具有一定的實力。醫院擁有一支經驗豐富的醫療團隊,設備和技術也相對先進。在服務方面,醫院注重患者的體驗,提供人性化的服務。在口碑方面,濰坊市中醫院也受到許多患者的好評。
3.濰坊醫學院附屬醫院:濰坊醫學院附屬醫院是一家集醫療、教學、科研于一體的綜合性醫院。在幹細胞治療領域,醫院具備一定的實力,擁有專業的醫療團隊和先進的設備。在服務方面,醫院也力求爲患者提供舒适的就醫環境。在口碑方面,濰坊醫學院附屬醫院同樣具有較高的認可度。
綜合以上分析,我們可以看出,濰坊市人民醫院、濰坊市中醫院和濰坊醫學院附屬醫院在幹細胞治療方面都具有一定的實力和口碑。其中,濰坊市人民醫院在設備、技術和口碑方面表現尤爲突出,可以認爲是濰坊地區口碑最佳的幹細胞醫院。
需要注意的是,選擇幹細胞醫院時,患者還需根據自身病情和需求,綜合對比各家醫院的實力和口碑,做出最适合自己的選擇。
-
上一頁: 國内幹細胞機構都有哪些知名企業?
-
下一頁: 哪家醫院在幹細胞移植倉領域領先?
- 2024-09-05河南肝硬化幹細胞移植醫院哪家好
- 2024-10-25哪家醫院在幹細胞移植倉領域領先?
- 2024-09-10遼甯丹東幹細胞捐獻機構有哪些
- 2024-09-05貝拉國際醫療中心是正規醫院嗎,貝拉國際醫療中心簡介
- 2024-10-16哪家醫院在幹細胞再生技術方面排名領先?
- 2024-11-15台州幹細胞移植醫院哪家比較好,如何進行選擇
- 2024-08-28幹細胞治療青光眼靠譜嗎,治療原理與效果介紹
- 2024-08-14移植造血幹細胞費用一次多少
- 2024-10-10幹細胞治療肝癌靠譜嗎,有哪些成功案例分享
- 2024-08-01幹細胞美容效果,幹細胞美容有什麽副作用
- 2024-07-27打一針幹細胞要多少錢,打一針幹細胞能管幾年
- 2024-08-05幹細胞治療腦梗,幹細胞治療腦梗效果怎麽樣
- 2024-08-26廣東幹細胞機構有哪些,廣東幹細胞機構名單公布
- 2024-09-03溫莎之謎幹細胞抗衰分析,幹細胞護膚品的作用和功效
- 2024-08-10幹細胞抗衰危險嗎能維持多久
- 2024-10-03臍帶血幹細胞移植費用,哪些因素影響其價格
- 2024-09-10蘋果幹細胞原液作用和使用注意事項
- 2024-08-28幹細胞治療肝硬化效果好嗎,費用多少
